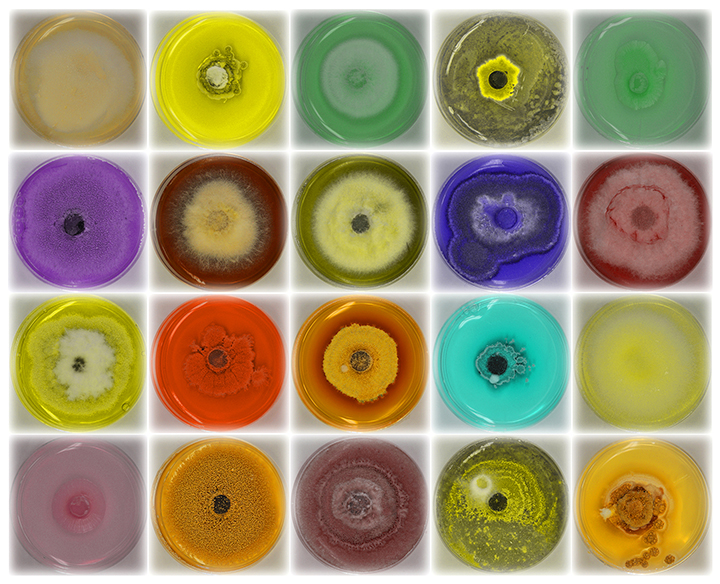

Art of Science
Two professors from the Watson School placed in the annual competition.
"Plates" by Congrui Jin took home the first place prize.
May 07, 2018
Binghamton University’s Art of Science competition features images by faculty, staff, students and postdocs that celebrate the beauty of science. For 2018, Mechanical Engineering Assistant Professor Congrui Jin’s submission won Best in Show. Distinguished Professor Jessica Fridrich from the Electrical and Computer Engineering Department also submitted a photo that received special recognition.
Posted in:
Science & Technology, Watson
